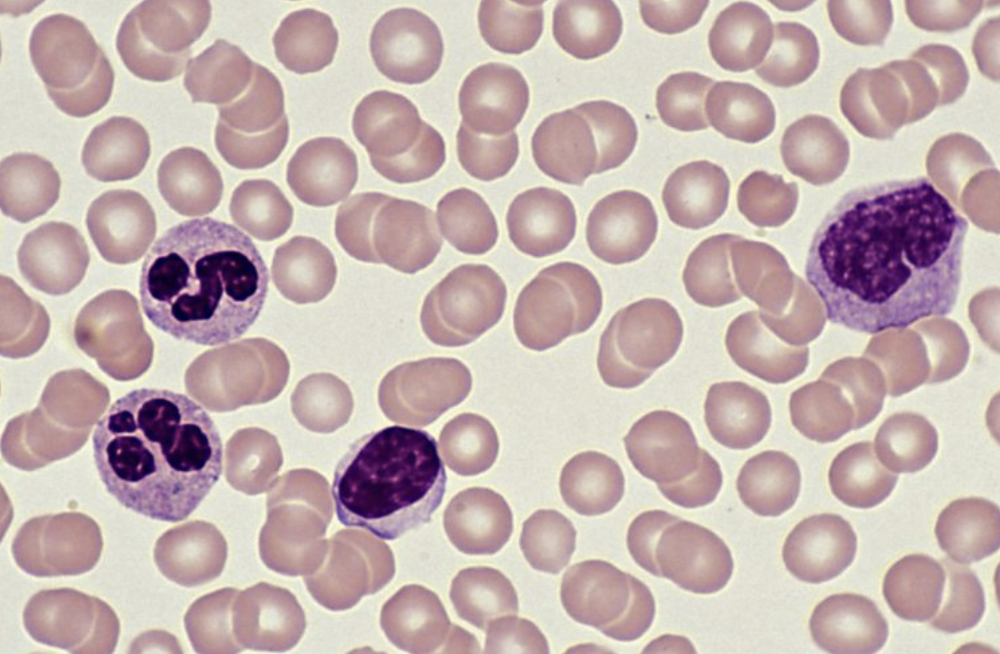

List the components of blood as and functions
- The primary role of red blood cells is to carry oxygen from the lungs to the rest of the body's tissues and transport carbon dioxide back to the lungs for exhalation. (these cells contain a protein called haemoglobin, which binds to oxygen, enabling efficient oxygen transport)
- White blood cells: Some white blood cells, called phagocytes, engulf and destroy pathogens (bacteria, viruses, etc.) through the process of phagocytosis. Lymphocytes, another type of white blood cell, produce antibodies.
- Platelets in clotting - preventing blood loss and the entry of pathogens.
- Plasma acts as a solvent allowing for the transport of blood cells, ions, nutrients, urea, hormones and carbon dioxide
Identify red and white blood cells and lymphocytes and phagocytes

Identifying Red Blood Cells:
- Shape: Look for the characteristic biconcave disc shape, which is thinner in the center than at the edges.
- Size: Red blood cells are typically smaller than white blood cells.
- Nucleus: Red blood cells lack a nucleus.
Identifying White Blood Cells:
- Shape: Generally round, but can vary in shape, especially phagocytes.
- Size: Larger than red blood cells.
- Nucleus: Visible nucleus, which can vary in shape and size depending on the type of white blood cell.
Identifying Lymphocytes and Phagocytes:
- Lymphocytes:These white blood cells have a large, round nucleus that takes up most of the cell, with a thin rim of cytoplasm.
- Phagocytes:These white blood cells can be identified by their irregular shape.
Describe the process of clotting
1. Clotting Factors and Thrombin:When a blood vessel is damaged, clotting factors are released, which ultimately leads to the activation of the enzyme thrombin.
2. Fibrinogen to Fibrin:Thrombin acts as a catalyst, converting the soluble plasma protein fibrinogen into insoluble fibrin.
3. Mesh Formation:Fibrin molecules then polymerize, forming long, insoluble threads that create a mesh-like network.
4. Clot Formation:This fibrin mesh traps platelets and blood cells, including red blood cells, forming a clot that seals the wound.
5. Scab Formation:Over time, the clot dries and hardens, forming a scab that protects the wound while new skin cells grow underneath.
Define a pathogen
A disease-causing organism.
Define a transmissible disease
A disease in which the pathogen can be passed from one host to another.
State how a pathogen is transmitted
(a) by direct contact, including through blood and other body fluids
(b) indirectly, including from contaminated surfaces, food, animals and air
Describe the body defences
- Skin: The skin is the body's outer covering and acts as the first line of defence. It is a physical barrier that prevents pathogens from entering the body.
- Nose Hairs: Act as a filter, trapping dust, dirt, and pathogens, preventing them from reaching the lungs.
- Mucus: Mucus is a sticky substance secreted by cells lining various body parts, including the respiratory and digestive tracts. It traps pathogens, preventing them from adhering to cells and causing infection. Mucus can be expelled from the body through coughing, sneezing, or swallowing.
- Stomach Acid:The stomach produces hydrochloric acid, which is highly acidic. This acidity creates an inhospitable environment for many pathogens, killing them before they can cause infection.
- White Blood Cells: They circulate in the blood and lymphatic system and are crucial for fighting infections. They can engulf and destroy pathogens or produce antibodies to neutralise them.
Define active immunity
Defence against a pathogen by antibody production in the body.
Define antibodies
Proteins that bind to antigens leading to direct destruction of pathogens or marking of pathogens for destruction by phagocytes.
Outline the process of vaccination
(a) weakened pathogens or their antigens are put into the body
(b) the antigens stimulate an immune response by lymphocytes which produce antibodies
(c) memory cells are produced that give long-term immunity
Define passive immunity
Passive immunity is a short-term defence against a pathogen by antibodies acquired from another individual, including across the placenta and in breast milk.
Describe cholera
A disease caused by bacteria which is transmitted in contaminated water.
The cholera bacterium produces a toxin that causes secretion of chloride ions into the small intestine, causing osmosis of water into the gut, causing diarrhoea, dehydration and loss of ions from the blood.
Describe the features of gas exchange surfaces in humans
limited to: large surface area, thin surface, good blood supply and good ventilation with air

Identify in diagrams and images the following parts of the breathing system:

Identify in diagrams and images the following parts of the breathing system: lungs, diaphragm, ribs, intercostal muscles, larynx, trachea, bronchi, bronchioles, alveoli and associated capillaries
Explain the role of the ribs, the internal and external intercostal muscles and the diaphragm in producing volume and pressure changes in the thorax leading to the ventilation of the lungs.
Overall process:
-
1. Inhalation:
- Diaphragm contracts
- External intercostal muscles contract
- Thoracic cavity volume increases
- Lung pressure decreases
- Air flows into the lungs
-
2. Exhalation:
- Diaphragm relaxes
- Internal intercostal muscles contract
- Thoracic cavity volume decreases
- Lung pressure increases
- Air is forced out of the lungs
-
Diaphragm:
- Inhalation: When the diaphragm contracts, it flattens downward, increasing the volume of the thoracic cavity. This creates a lower pressure in the lungs relative to atmospheric pressure, causing air to flow in.
- Exhalation: When the diaphragm relaxes, it moves upward, decreasing the thoracic volume and increasing lung pressure, forcing air out.
-
External Intercostal Muscles:
- Inhalation: These muscles contract, pulling the ribs upward and outward, which expands the thoracic cavity and contributes to lowering lung pressure.
-
Internal Intercostal Muscles:
- Exhalation: These muscles contract, pulling the ribs downward and inward, which decreases the thoracic volume and increases lung pressure, forcing air out.
Explain the differences in composition between inspired and expired air
Inspired air has more oxygen (about 21%) and less carbon dioxide (about 0.04%).
Expired air has less oxygen (around 16%) and more carbon dioxide (around 4%), along with more water vapor and a higher temperature.
Explain the link between physical activity and the rate and depth of breathing
An increased carbon dioxide concentration due to muscles working harder and more as a waste product in the blood, which is detected by the brain, leading to an increased rate and greater depth of breathing.
Explain the role in protecting the breathing system from pathogens and particles
Goblet cells produce sticky mucus that traps pathogens and particles, while ciliated cells have hair-like cilia that beat to sweep this mucus, and its trapped contents, up the airways towards the throat to be swallowed and destroyed.
State the uses of energy in living organisms, including
- Muscle contraction:Energy is required to power the movement of muscles, allowing us to walk, run, and perform other physical activities.
- Protein synthesis:The creation of new proteins, which are essential for building and repairing tissues, requires energy to drive the complex process of translation.
- Cell division:When cells divide to produce new cells, energy is needed to replicate DNA and carry out the other processes involved in cell division.
- Active transport:Moving molecules across cell membranes against a concentration gradient requires energy input, as this is not a passive process.
- Growth:Organisms need energy to synthesize new materials and increase in size.
- Passage of nerve impulses:The transmission of electrical signals along nerves requires energy to maintain the proper membrane potentials.
- Maintenance of a constant body temperature:Warm-blooded animals need energy to generate heat and maintain a stable internal temperature.
Describe aerobic respiration and equation
The chemical reactions in cells that use oxygen to break down nutrient molecules to release energy.
glucose + oxygen → carbon dioxide + water
C6H12O6 + 6O2 → 6CO2 + 6H2O
Describe anaerobic respiration and 2 equations
The chemical reactions in cells that break down nutrient molecules to release energy without using oxygen. *Anaerobic respiration releases much less energy per glucose molecule than aerobic respiration.
State the word equation for anaerobic respiration in yeast as:
glucose → alcohol + carbon dioxide (C6H12O6 → 2C2H5OH + 2CO2)
State the word equation for anaerobic respiration in muscles during vigorous exercise as:
glucose → lactic acid
*lactic acid builds up in muscles and blood during vigorous exercise causing an oxygen debt
To help oxygen debt:
(a) continuation of fast heart rate to transport lactic acid in the blood from the muscles to the liver
(b) continuation of deeper and faster breathing to supply oxygen for aerobic respiration of lactic acid
(c) aerobic respiration of lactic acid in the liver

Identify in diagrams and images the structure of the kidney and bladder etc.

Identify in diagrams and images the kidneys, ureters, bladder and urethra
Identify in diagrams and images the structure of the kidney, limited to the cortex and medulla
Outline the structure and function of a nephron and its associated blood vessels.

(a) the role of the glomerulus in the filtration from the blood of water, glucose, urea and ions
(b) the role of the nephron in the reabsorption of all of the glucose, some of the ions and most of the water back into the blood
(c) the formation of urine containing urea, excess water and excess ions
Describe role of liver in excretion including definition for deamination.
Assimilation:
- After digestion, amino acids are absorbed into the bloodstream and transported to the liver.
- In the liver, amino acids are used to synthesize new proteins.
- urea is formed in the liver from excess amino acids (deamination)
Describe deamination as the removal of the nitrogen-containing part of amino acids to form urea.
Excretion of urea is vital because urea's accumulation can poison cells, disrupt metabolic processes, and eventually lead to organ failure.
What travels along neurones?
electrical impulses
Describe the mammalian nervous system and its role
(a) the central nervous system (CNS) consisting of the brain and the spinal cord
(b) the peripheral nervous system (PNS) consisting of the nerves outside of the brain and spinal cord
*the role of the nervous system as coordination and regulation of body functions
Describe the events at a synapse and definition
A junction between two neurones.
(a) an impulse stimulates the release of neurotransmitter molecules from vesicles into the synaptic gap
(b) the neurotransmitter molecules diffuse across the gap
(c) neurotransmitter molecules bind with receptor proteins on the next neurone
(d) an impulse is then stimulated in the next neurone
*Synapses ensure that impulses travel in one direction only
Define a reflex action
A means of automatically and rapidly integrating and coordinating stimuli with the responses of effectors (muscles and glands).
Describe a simple reflex arc in terms of: receptor, sensory neurone, relay neurone, motor neurone and effector
- 1. Stimulus:A change in the environment, such as touching a hot object, that triggers the reflex.
- 2. Receptor: Specialised cells (e.g., thermoreceptors in the skin) that detect the stimulus.
- 3. Sensory Neurone: Carries the electrical impulse from the receptor to the spinal cord (or other part of the CNS).
- 4. Relay Neurone (Interneurone): Located within the CNS, it connects the sensory neurone to the motor neurone, passing the impulse along.
- 5. Motor Neurone: Carries the electrical impulse from the CNS to the effector.
- 6. Effector :A muscle or gland that responds to the impulse, producing the action, such as muscle contraction to pull away from the heat.
Describe the structure of a synapse



Sensory neurones are long, have a cell body branching from the middle of the axon, and carry impulses from receptors to the CNS;
relay neurones are short, found within the CNS, and connect sensory to motor neurones;
motor neurones are long, with a cell body at one end and long dendrites, carrying impulses from the CNS to effectors like muscles or glands.
Define sense organs
Groups of receptor cells responding to specific stimuli: light, sound, touch, temperature and chemicals.

Identify in diagrams and images the structures of the eye

cornea, iris, pupil, lens, retina, optic nerve and blind spot
Describe the function of each part of the eye, limited to:
(a) cornea
(b) iris
(c) lens
(d) retina
(e) optic nerve
(a) cornea – refracts light
(b) iris – controls how much light enters the pupil
(c) lens – focuses light on to the retina
(d) retina – contains light receptors, some sensitive to light of different colours
(e) optic nerve – carries impulses to the brain
Explain the pupil reflex

Antagonistic muscles: are pairs of muscles that work in opposite ways; when one contracts, the other relaxes.
In Bright Light: The circular muscles contract, while the radial muscles relax which shrinks the pupil allowing less light to enter the eye, protecting the retina.
In Dim Light: The radial muscles contract, while the circular muscles relax causing the pupil to dilate (widen). A larger pupil allows more light to enter the eye, helping the eye to see in low-light conditions.
Explain accommodation to view near and distant objects, how eye changes

For distant objects, the ciliary muscles relax, tightening the suspensory ligaments and making the lens thinner and flatter, which reduces light refraction.
For near objects, the ciliary muscles contract, relaxing the suspensory ligaments and allowing the elastic lens to become thicker and more convex, increasing its refractive power to focus the light.
Function and distribution of rods and cones
Rods
- Function: Rods are highly sensitive to light and are responsible for night vision. They do not detect colour, which is why we see in shades of gray in the dark.
- Distribution:Rods are primarily located in the periphery of the retina, away from the center.
Cones
- Function: Cones are responsible for colour vision and (sharpness) in bright light. There are three types of cones, each sensitive to different wavelengths of light (red, green, or blue).
- Distribution: Cones are concentrated in the fovea, a small pit in the center of the retina, where their density is highest. They are less dense in the rest of the retina compared to rods.
Define a hormone
A chemical substance, produced by a gland and carried by the blood, which alters the activity of one or more specific target organs.
Identify in diagrams and state the hormones they secrete, limited to: adrenaline, insulin, testosterone, oestrogen and glucagon

(a) adrenal glands and adrenaline
(b) pancreas and insulin
(c) testes and testosterone
(d) ovaries and oestrogen
(e) glucagon is secreted by the pancreas
Define adrenaline and its effects,
the hormone secreted in ‘fight or flight’ situations
(a) increased breathing rate
(b) increased heart rate
(c) increased pupil diameter
(d) increasing the blood glucose concentration
Compare nervous and hormonal control, limited to speed of action and duration of effect
Nervous control is characterised by very fast, almost instantaneous responses that are short-lived.
Hormonal control is a slower process involving chemical signals (hormones) transported via the bloodstream, resulting in longer-lasting effects on the body's tissues and organs.
Define homeostasis and how it works
The maintenance of a constant internal environment.
Homeostatic control uses negative feedback to keep internal body conditions stable around a fixed set point.When a condition, like blood glucose, deviates from its set point, receptors detect the change. This triggers a correction mechanism, such as the release of insulin, that acts in the opposite direction of the initial change to bring the condition back to its set point, after which the mechanism is switched off.
what does insulin do
and how liver controls blood glucose concentration
decreases blood glucose concentration
The liver controls blood glucose through the action of insulin and glucagon, produced by the pancreas, in a negative feedback loop.
When blood glucose is high, insulin stimulates the liver to store excess glucose as glycogen.
When blood glucose is low, glucagon stimulates the liver to break down stored glycogen into glucose, which is released into the blood.
Outline the treatment of Type 1 diabetes
Treatment for Type 1 diabetes involves lifelong management to control blood glucose levels,
through insulin injections or insulin pump therapy, monitor their blood sugar regularly, follow a balanced diet to manage carbohydrate intake, and engage in regular exercise to help lower blood glucose levels.

Identify in diagrams and images of the skin: hairs, hair erector muscles, sweat glands, receptors, sensory neurones, blood vessels and fatty tissue

Describe methods for the maintenance of a constant internal body temperature
Mammals maintain a constant internal temperature (thermoregulation) through a feedback system controlled by the hypothalamus in the brain, using mechanisms like
insulation (fur/fat to trap air),
sweating (evaporative heat loss)
shivering (muscle activity to generate heat)
vasodilation (widening of blood vessels for heat loss) : This increases blood flow to the skin, allowing more heat to be radiated, conducted, or convected away from the body.
vasoconstriction (narrowing of blood vessels for heat conservation) of skin capillaries : This reduces blood flow to the skin, minimizing heat loss to the environment and conserving the body's core heat.
Define gravitropism
A response in which parts of a plant grow towards or away from gravity.
Define phototropism
A response in which parts of a plant grow towards or away from the direction of the light source.
Explain phototropism and gravitropism
Phototropism
- Mechanism: Light causes auxin to move away from the light source and accumulate on the shaded side of the plant.
- In Shoots (Positive Phototropism):The higher auxin concentration on the shaded side promotes greater cell elongation, causing the shoot to bend towards the light for photosynthesis.
Gravitropism
- Mechanism: Gravity causes auxin to accumulate on the lower side of both shoots and roots.
- In Shoots (Negative Gravitropism):The higher auxin concentration on the lower side promotes cell elongation more rapidly, causing the shoot to bend upwards, away from gravity.
- In Roots (Positive Gravitropism):The higher auxin concentration on the lower side inhibits cell elongation. This slower growth on the bottom compared to the upper side causes the root to bend downwards, in the direction of gravity.
- Purpose:Negative gravitropism in shoots helps leaves reach sunlight, while positive gravitropism in roots anchors the plant and helps it find water and minerals.
It is a chemical control of plant growth
Describe auxin
(a) auxin is made in the shoot tip
(b) auxin diffuses through the plant from the shoot tip
(c) auxin is unequally distributed in response to light and gravity
(d) auxin stimulates cell elongation
Describe experiment for phototropism and gravitropism
- Materials: Bean seedlings, pots, boxes with holes in the side, lamps, water, and fertilizer.
- Setup: Place seedlings in pots inside the boxes.
-
Conditions:
- Phototropism Experiment: Place a light source to one side of the box so the light enters through a hole.
- Gravitropism Experiment: Place a plant in a pot and place it in a fixed position to show positive geotropism.
- Observation: Water both plants and allow them to grow for several days.
-
Expected Results:
- Phototropism: The shoot will bend and grow towards the light source.
- Gravitropism: Roots will grow downwards towards the gravitational pull, while shoots will grow upwards.
How temperature effects yeast respiration
A moderate temperature increase accelerates the rate by increasing enzyme kinetic energy and reaction speed. However, beyond an optimal point (often around 25-35°C, depending on the yeast strain), enzymes denature, and the rate of respiration rapidly slows and eventually stops.